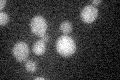
YDR016C
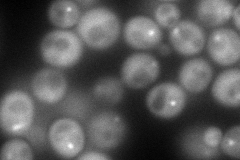
YDR016C
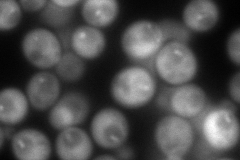
YDR016C
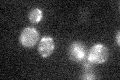
YDR016C

View description
Essential subunit of the Dam1 complex (aka DASH complex), couples kinetochores to the force produced by MT depolymerization thereby aiding in chromosome segregation; is transferred to the kinetochore prior to mitosis
Localization:
Intensity:
Fold change:
Significance:
-
C’ GFP library in SD
below threshold15.28 -
N' NOP1pr-GFP in SD
cytosol,punctate159.814 -
N' TEF2pr-mCherry in SD
punctate243.67 -
N' NATIVEpr-GFP in SD

punctate28.856 -
N' TEF2pr-VC and Cyto-VN in SD

punctate38.0668 -
C’ GFP library in SD+DTT

cytosol11.870.77No -
C’ GFP library in SD+H2O2
cytosol16.721.09No -
C’ GFP library in Starvation Media

cytosol15.971.04No -
C’ GFP library on the background of Pup2-DaMP

below threshold -
C’ GFP library on the background of CCT mutant

below threshold14.64120.957731No
